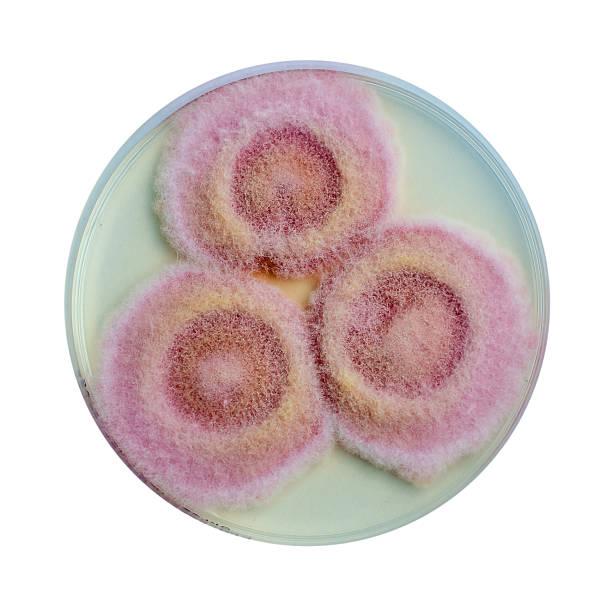

Dextrose is one of the most widely utilized carbohydrates in global manufacturing industries. Derived from the hydrolysis of starch, particularly corn starch, dextrose is valued for its ability to provide sweetness, enhance flavor stability, and supply quick energy. These characteristics make it an essential ingredient in the food and beverage sector, pharmaceutical formulations, and various industrial applications. As the demand for processed foods and healthcare solutions increases worldwide, the relevance of dextrose continues to grow across multiple sectors.
In food processing, dextrose plays a significant functional role. It is commonly used in bakery products, confectionery, dairy items, and beverages. Because dextrose dissolves easily and provides mild sweetness, manufacturers frequently incorporate it into products that require consistent flavor and texture. In baked goods, dextrose assists with yeast fermentation, helping dough rise effectively while also contributing to desirable browning during baking.
Recent findings from Dextrose market size highlight the increasing consumption of processed foods as a major factor driving industry growth. Rapid urbanization and busy lifestyles have encouraged consumers to rely more heavily on packaged and ready-to-eat foods. These products require reliable ingredients that improve taste and shelf life, making dextrose an important component in modern food formulations.
The pharmaceutical industry also represents a critical application area. Dextrose is widely used in intravenous fluids, medical nutrition products, and treatments designed to restore blood glucose levels. Healthcare professionals often administer dextrose solutions to patients experiencing dehydration or hypoglycemia. Because the body absorbs dextrose quickly, it provides an efficient source of energy during medical treatments and recovery processes.
Geographically, the market shows varied patterns of demand. North America has historically maintained a strong presence due to its large-scale corn production and advanced food processing sector. Europe also remains an established market supported by robust pharmaceutical manufacturing. Meanwhile, Asia-Pacific is emerging as a significant growth region. Population growth, industrial expansion, and increasing demand for packaged foods are contributing to rising consumption levels in countries such as China and India.
Technological innovation is further strengthening the industry. Advances in enzymatic conversion processes allow manufacturers to improve efficiency and reduce production costs. These improvements help companies produce higher volumes of dextrose while maintaining strict quality standards required by food and pharmaceutical industries.
However, the industry faces certain challenges that may influence future development. Fluctuations in raw material prices, particularly corn, can impact production expenses. In addition, growing consumer awareness regarding sugar consumption has prompted food manufacturers to explore alternative sweeteners and reduced-sugar formulations. Despite these factors, dextrose continues to be widely used because of its functional benefits and cost efficiency.
In summary, the dextrose industry remains an important part of the global ingredient market. Its broad range of applications across food processing and healthcare ensures sustained demand. As manufacturing technologies improve and global food consumption continues to rise, dextrose will likely remain a valuable ingredient in numerous industrial processes.
Browse More Report: